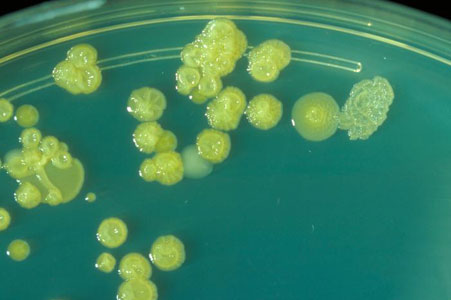

Hello Hello,
I hope that you are doing well. This month we have an article by Dr. Michael Berg discussing MRSA and another article by Dr. Michelle Seidl discussing coliform bacteria. I hope you find them interesting and useful.
With best wishes,
Dave Gallup
Methicillin-resistant Staphylococcus aureus (MRSA)
By Dr. Michael Berg, EMLab P&K Senior Molecular Biologist
Overview
Methicillin-resistant Staphylococcus aureus (MRSA) is a variation of the common bacterium Staphylococcus aureus. Staphylococcus bacteria frequently live on the skin and in the nose of humans without causing any health problems. Approximately one third of the world's population has S. aureus bacteria on their body at any given time. According to the Centers for Disease Control and Prevention (CDC), about 1% of people carrying S. aureus have MRSA. Staphylococcus bacteria can be spread from one person to another through casual contact or contaminated objects and become a problem when they are a source for infection. MRSA infections are more difficult to treat than ordinary Staphylococcus infections because MRSA is resistant to the widely used beta-lactam antibiotics, including penicillin and methicillin. Methicillin-resistant strains still respond to other antibiotics such as vancomycin but, although rare, vancomycin-resistant MRSA have been reported. Typically, infections occur in wounds, burns and when tubes have been inserted into the body. In the U.S., there are an estimated 94,000 cases of MRSA infections every year and nearly 19,000 deaths.
Most infections with MRSA occur in hospitals and healthcare facilities, often in patients who have a weakened immune system. Hospital-acquired (HA)-MRSA infections include surgical would infections, urinary tract infections, blood stream infections and pneumonia. MRSA infections of people who have not been recently hospitalized are known as community-acquired (CA)-MRSA infections. Risk factors for CA-MRSA infections include participation in contact sports, sharing athletic equipment or personal items, living in crowded and/or unsanitary conditions, young age and having a weakened immune system.

Scanning electron micrograph (SEM) depicting numerous clumps of methicillin-resistant Staphylococcus aureus bacteria, commonly referred to by the acronym, MRSA; Magnified 9560x.
Source: Centers for Disease Control and Prevention
Community-acquired (CA)-MRSA
CA-MRSA has recently drawn national attention in the news media after a 17-year-old high school student in Virginia died from an infection. MRSA often appears as soft tissue infection, such as a boil or abscess. The affected skin area may be red, swollen, and painful, sometimes containing pus or drainage. It can also cause more serious infections of the bloodstream or the respiratory tract, leading to a variety of other symptoms including shortness of breath, fever, chills, and death. CA-MRSA typically enters the body through a cut or scrape and can quickly cause a widespread infection. Especially children are at high risk because their immune system is not fully developed. Healthcare workers and people with close contact to healthcare workers as well as participants of contact sports have a higher risk of MRSA infection since the bacteria easily spread through cuts and abrasions, skin-to-skin contact, and even by sharing sweaty towels. Outbreaks of CA-MRSA have also occurred in military training camps, prisons, child-and long-term care facilities and generally in places where crowding and unsanitary conditions may be an issue.
Microbiology
Staphylococci are Gram-positive clump-forming bacteria about 0.5-1µm in diameter and grow in clusters, pairs and occasionally in short chains. They are catalase positive, often haemolytic and salt-tolerant. In contrast to all other Staphylococci, S. aureus and S. intermedius are coagulase positive. S. aureus became methicillin-resistant (MRSA) by acquiring a mecA gene, which usually resides on a larger piece of DNA called a staphylococcal cassette chromosome SCCmec. Recent outbreaks of CA-MRSA seem to be caused by isolates that also carry the genes for a toxin (PVL) known to cause lysis of white blood cells.
Infections and Symptoms
Staphyloccoci tend to infect the skin but they can travel through the bloodstream and involve almost any site in the body, particularly the heart and the bones. They can also infect the respiratory tract, mainly in people with chronic lung disease or influenza and lead to staphylococcal pneumonia. Some strains of staphylococci produce toxins that can lead to food poisoning, toxic shock syndrome, and scalded skin syndrome. Skin infections caused by staphylococci range from folliculitis, an infection of a hair root that produces a tiny white pimple, fluid-filled blisters (impetigo) and painful skin abscesses to staphylococcal cellulites, toxic necrolysis and scalded skin syndrome in newborns. The latter two infections lead to large-scale peeling of the skin. Symptoms of staphylococcal pneumonia are high fever, shortness of breath, rapid breathing, and coughing that may include blood. Other severe and life-threatening infections with staphylococci include victims of severs burns (bacteremia) and heart infections (endocarditis) that can quickly lead to heart failure and death.
Diagnosis and Prevention
Testing of clinical samples for MRSA is usually done by obtaining a sample from an infection site or by a nasal swab. The samples are then sent to a clinical microbiology laboratory for further testing, which typically involves growing the bacterial culture on selective media. Environmental samples are collected by swabbing items that are frequently touched such as door knobs, keyboards, athletic equipment etc. EMLabP&K offers MRSA-testing by culture analysis on environmental samples. Prevention of HA-MRSA includes washing hands (staff and patient) frequently and making sure that tubes and catheters are inserted and removed under sterile conditions. CA-MRSA can be reduced by keeping personal items personal, washing hands frequently, keeping wounds covered, sanitizing items and getting tested.
References:
1. Wikipedia: Methicillin-resistant Staphylococcus aureus
2. Mayo Clinic: MRSA Infection
3. NIAID: Methicillin-Resistant Staphylococcus aureus
4. MedlinePlus: MRSA
Coliform Bacteria Other Than E. Coli: Enterobacter, Klebsiella and Citrobacter
By Dr. Michelle Seidl, EMLab P&K Mycologist
Coliform bacteria, as the name suggests, commonly inhabit the colons of humans and other vertebrates. They are generally Gram-negative, rod-shaped (bacilli) bacteria that ferment lactose with gas formation within 48 hours at 35°C. These microbes are facultative anaerobes, thus can survive without oxygen but are not harmed in the presence of oxygen. While many are normal inhabitants of the gastrointestinal (GI) tract and considered relatively harmless, others include overt and opportunistic pathogens responsible for a wide range of infections. Bacteria in this group belong to the Enterobacteriaceae family and include Escherichia, Klebsiella, Enterobacter, Citrobacter, Serratia and Proteus. Within the larger group of coliforms, fecal coliforms are a subset (i.e. Escherichia coli and Klebsiella) found in animal wastes and human sewage. Some of these are nonpathogenic (i.e. E. coli), while others are pathogenic (i.e. E. coli strain O157:H7). These bacteria occur in large numbers and typically live and reproduce symbiotically in the digestive tracts of warm-blooded animals. Absence in humans can lead to various types of vitamin deficiencies. Throughout the environment, these bacteria are found in places such as soil, surface water and vegetation. Coliforms enter streams and lakes with human sewage or animal wastes. The presence or detection of coliform bacteria is an indicator of pollution and of potentially dangerous contamination. Although most coliform bacteria are harmless, some can cause health problems including diarrhea, cramps, nausea and vomiting. Together these symptoms comprise a general category known as gastroenteritis, which is not usually serious for a healthy person, but can lead to more serious problems for people with weakened immune systems. The epidemiology of coliform infections is complex and involves multiple reservoirs and modes of transmission, which is beyond the scope of this article. Selected coliform bacterial genera (other than Escherichia) are briefly summarized below: Klebsiella, Enterobacter and Citrobacter.
Klebsiella is a genus of non-motile, Gram-negative bacilli, 0.3-1 micron wide by 0.6-6 microns long, producing slimy colonies and cells have a prominent polysaccharide-based capsule. Frequent human pathogens, Klebsiella species can lead to a wide range of disease states, notably pneumonia, urinary tract infections, septicemia (blood poisoning or pathogenic bacteria in the bloodstream), and soft tissue infections. Infections with this organism may also play a role in ankylosing spondylitis (inflammation of the vertebrae). Occurring in the human gastrointestinal tract, Klebsiella is important for normal bowel health and function. The problem with Klebsiella bacteria occurs when it gets outside of the human colon where serious infection can occur. As a general rule, Klebsiella infections tend to occur in people with a weakened immune system and/or with underlying diseases such as alcoholism, diabetes and chronic lung diseases. Many of these infections are obtained when a person is in the hospital for some other reason. The most common infection caused by Klebsiella bacteria is pneumonia. Classically, Klebsiella pneumonia causes a severe, rapid-onset illness that often leads to areas of destruction in the lung. Infected persons generally get high fever, chills, flu-like symptoms and a cough. Mortality in Klebsiella pneumonia is fairly high due to the underlying disease that tends to be present in affected persons. While normal pneumonia frequently resolves without complication, Klebsiella pneumonia can cause permanent lung damage. In addition, Klebsiella can also cause less serious respiratory infections, such as bronchitis, which is usually a hospital-acquired infection. Other common hospital-acquired infections caused by Klebsiella are urinary tract infections, surgical wound infections and infection of the blood. Klebsiella bacteria are generally resistant to many antibiotics, such as penicillin. Often two or more powerful antibiotics are used to help eliminate a Klebsiella infection.
Trypticase soy agar plate culture of E. sakazakii showing wrinkled colonies after three days at 25°C.
Source: Centers for Disease Control and Prevention
Enterobacter is a genus of motile, Gram-negative bacilli, measuring 0.6-1 micron wide by 1.2-3 microns long. Closely related to Klebsiella, the Enterobacter bacteria can be distinguished by motility and their ability to decarboxylate ornithine. Enterobacter colonies are either raised or mucoid (slime-forming). Generally not a problem in healthy individuals, they are opportunistic pathogens in people with compromised immune systems, especially in hospitals where infection control has broken down, including seldom or improper hand-washing or cross-transmission. There are several Enterobacter species, differentiated by their ability to ferment particular sugars and possession of arginine dihydrolase, lysine and ornithine decarboxylase. Enterobacter cloacae, and to a lesser degree, E. aerogenes, are the most common pathogenic species in this genus. A less common species, E. sakazakii, forms bright yellow colonies and is one of the causal agents for infections in newborns and for meningitis. Treatment for Enterobacter infections is primarily with carbapenems and cefepime, but may also include combination chemotherapy. Hand washing is still the most important way to prevent Enterobacter infection. Beneficial uses include Enterobacter cloacae, which has been used in biological control of plant diseases, notably the seed-rotting water mold, Pythium ultimum.
Citrobacter is a genus of motile, Gram-negative bacilli, measuring 1 micron wide by 2-6 microns long. Composed of about 12 species, these coliforms can use citrate as their sole carbon source. They can be found throughout the environment including soil, water, wastewater and part of the normal human GI tract. They are rarely the source of illnesses, but have been associated with diarrhea, urinary tract infections and infant meningitis. They also occasionally cause severe bloodstream infections (bacteremia). The most commonly isolated species is C. freundii. In addition, Citrobacter shows the ability to accumulate uranium by building phosphate complexes.
References:
1. Guentzel, M. N. 1996. Escherichia, Klebsiella, Enterobacter, Serratia, Citrobacter, and Proteus. In: Barron's Medical Microbiology (Barron, S., et al, eds.), 4th ed., Univ. of Texas Medical Branch.
2. Holt, John G. 1994. Bergey's Manual of Determinative Bacteriology. 9th Edition. Lippincott Williams & Wilkins: Philadelphia.
3. PersonalMD
4. Health Protection Agency: Citrobacter